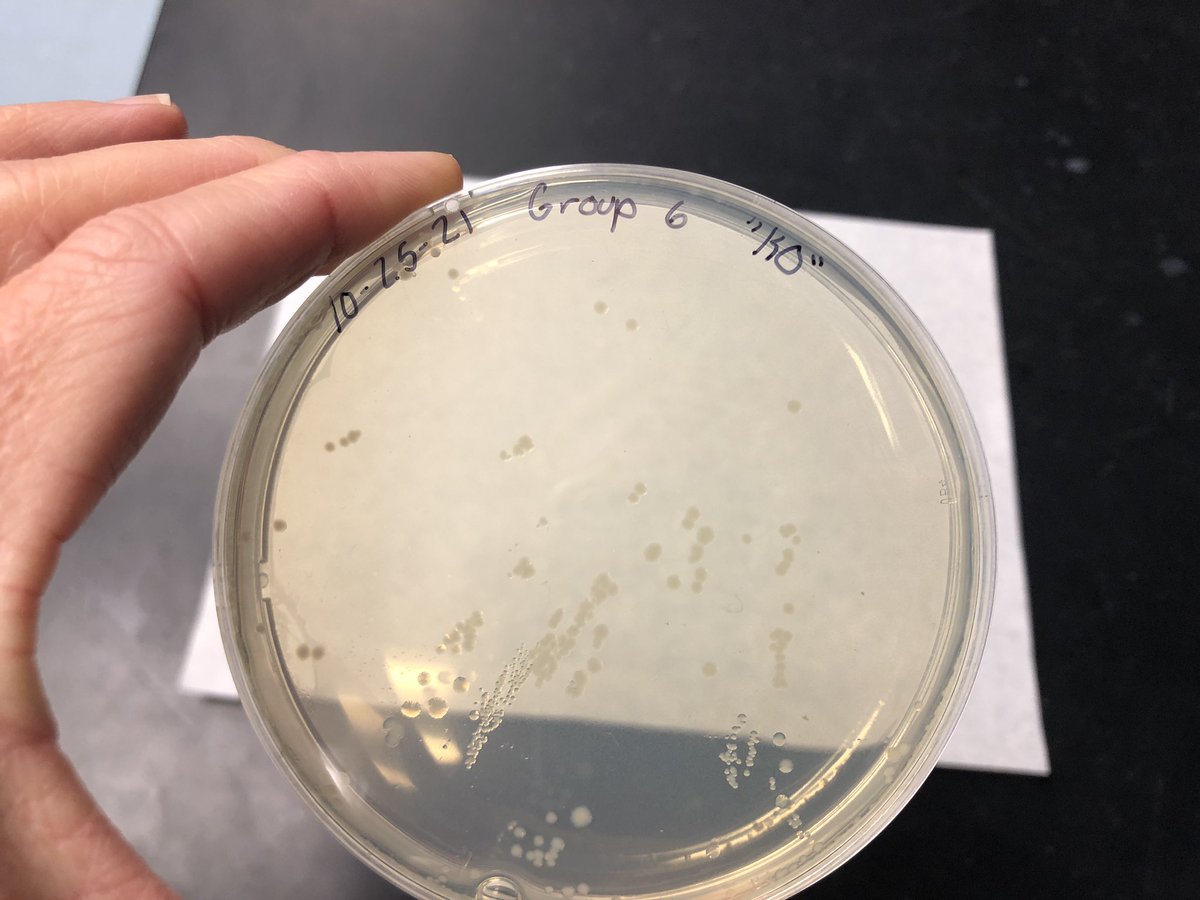
The kids got great results with the new <a href="/miniPCR/">miniPCR bio</a> CRISPR “Knockout” lab! The control metabolizes a sugar that makes the cells blue, while CRISPR/Cas9 in KO cells makes them unable to digest the sugar so the cells stay white. It’s going to be a good week!!! <a href="/AndoverHS_Princ/">Caitlin Brown</a>

Lindsey LEcuyer
@ahsbiotech
Grower of fellow biology enthusiasts at Andover High School. Runner. Zoe's mom.
ID: 719695032601718784
12-04-2016 01:14:01
535 Tweet
294 Followers
562 Following

#BioBuilder club kickoff today! We opened with discussing NISE Network Tech Tokens: where would you invest? What are the stakeholders’ perspectives? (My money is on $DNA Ginkgo Bioworks !) 🧬👨🔬👩🔬🧫 Systems Sally Caitlin Brown



The kids got great results with the new miniPCR bio CRISPR “Knockout” lab! The control metabolizes a sugar that makes the cells blue, while CRISPR/Cas9 in KO cells makes them unable to digest the sugar so the cells stay white. It’s going to be a good week!!! Caitlin Brown

Really wonderful to wish #BioBuilder a happy 10th birthday this evening. Beautiful event, passionate people, inspiration for horizons ahead. 🥳 Systems Sally


The BioBits® results are in: kids love learning about the central dogma this way! Relevant, rigorous, hands-on phenomena to pique their interest. Ally Huang, PhD miniPCR bio 💕🧬


#BioBuilderClub students had a great visit from a parent who works at Pfizer, who shared the exciting world of large molecule production from cells. 🧬🧬🧬 Caitlin Brown


SO MUCH SCIENCE. Amplifying our sleep alleles, pouring gels, finishing up synthetic biology presentations. “I really like all this multitasking” exclaimed one student. Living the dream! 😍🧬🤓🥳 miniPCR bio




Biotech students really enjoyed meeting with miniPCR bio Ally Huang, PhD about her career path that led her to BioBits® . Takeaways? Be flexible, make mistakes, do things not because it looks good, but because you enjoy them. 🧬🧫🧑🔬👊🏻 Caitlin Brown




These yellow submarines are music to our ears!! Spinning corn chip DNA for the miniPCR bio GMO lab. Stay tuned for tomorrow results! 👀😍🌽🧬

End of #BioBuilderClub photo to say farewell to our seniors, as well as visits from ‘21 members to talk about their plans for summer research - The McGill iGEM team joined virtually to give us a sweet tour of the lab! 🧬🧫 Systems Sally Caitlin Brown


#BioBuilderClub students met with Dr. Robbie Wilson at MIT about rubisco engineering that could enhance photosynthesis to decrease global warming. We then traveled to the BioBuilder learning lab with Systems Sally and toured Ginkgo Bioworks . An inspiring afternoon!! Caitlin Brown



LOVE this #BioBuilder Colorful World transformation/engineering discussion in biotech class. What is the effect of chassis on gene expression? Which design would you choose if you had to make bio paint?? Systems Sally





